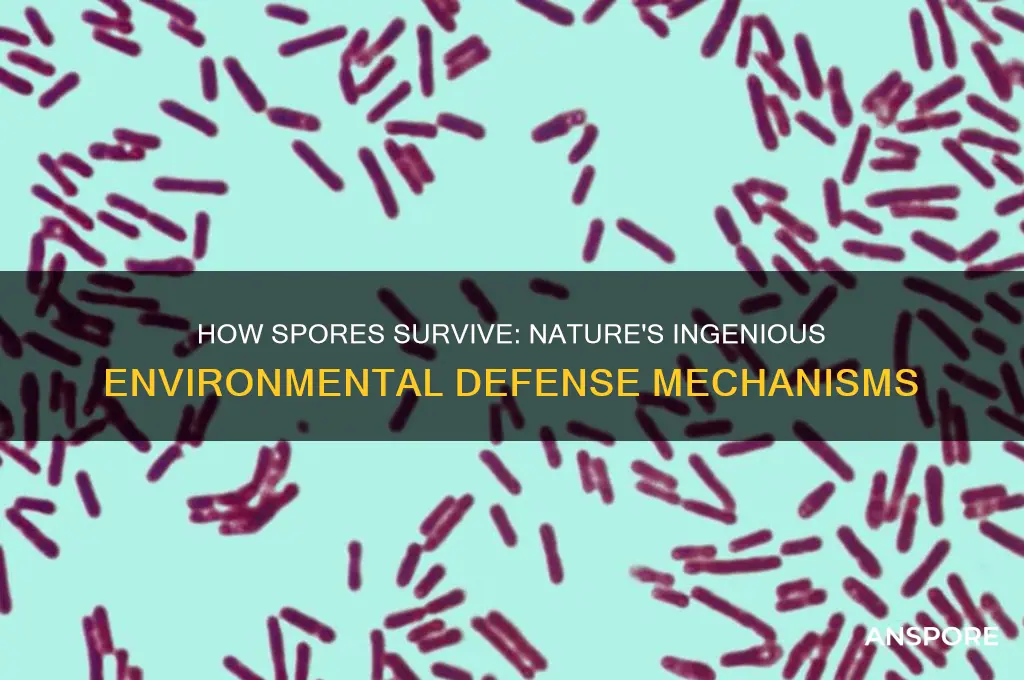
how do spores protect themselves from the environment

Spores are highly specialized survival structures produced by various organisms, including bacteria, fungi, and plants, to withstand harsh environmental conditions. They are designed to remain dormant for extended periods, often enduring extreme temperatures, desiccation, radiation, and chemical exposure. This resilience is achieved through several protective mechanisms: spores have thick, impermeable cell walls composed of durable materials like sporopollenin or peptidoglycan, which shield their genetic material from damage. Additionally, they often contain high concentrations of protective molecules such as dipicolinic acid and trehalose, which stabilize cellular structures and prevent DNA degradation. Their small size and lightweight nature also enable dispersal over long distances, increasing their chances of finding favorable conditions for germination. Together, these adaptations ensure spores can persist in inhospitable environments until conditions improve, making them a key strategy for survival and propagation in the natural world.
Explore related products
What You'll Learn
- Thick Cell Wall: Spores have a robust cell wall that shields against physical damage and environmental stressors
- Dormancy Mechanism: Spores enter a dormant state, reducing metabolic activity to survive harsh conditions
- Pigmentation: Dark pigments in spores protect against UV radiation, preventing DNA damage
- Small Size: Compact size minimizes surface area, reducing exposure to harmful environmental factors
- Resistant Coatings: Spores produce protective layers like exosporium to resist heat, chemicals, and desiccation

Thick Cell Wall: Spores have a robust cell wall that shields against physical damage and environmental stressors
Spores, the resilient survival structures of certain bacteria, fungi, and plants, owe much of their durability to a thick, robust cell wall. This biological fortress is not merely a passive barrier but a dynamic shield engineered to withstand extreme conditions. Composed primarily of layers of peptidoglycan in bacteria and chitin in fungi, this wall provides structural integrity that resists mechanical stress, such as crushing forces or abrasion. For instance, bacterial endospores, like those of *Bacillus anthracis*, can survive being ground into fine powders without losing viability, a testament to the wall’s toughness.
To understand the wall’s protective mechanism, consider its multi-layered architecture. The outermost layer often includes spore-specific proteins and lipids that repel water and toxins, acting as a chemical barrier. Beneath this lies a cortex rich in peptidoglycan, which provides rigidity and resists osmotic pressure. In some spores, like those of *Clostridium botulinum*, the wall’s thickness can be up to 100 nm, significantly greater than that of vegetative cells. This thickness is not arbitrary; it’s a precise adaptation to endure desiccation, radiation, and temperature extremes.
Practical applications of this knowledge are vast. For example, in food preservation, understanding how spore walls resist heat allows for targeted sterilization techniques. Autoclaving at 121°C for 15–20 minutes is standard to destroy bacterial spores, but this relies on breaching the wall’s defenses. Conversely, in agriculture, harnessing spore resilience can improve crop survival in harsh climates. Coating seeds with spore-inspired polymers could mimic the wall’s protective properties, enhancing germination rates in arid or saline soils.
However, the very strength of spore walls poses challenges, particularly in medical contexts. Antibiotics struggle to penetrate this barrier, making spore-forming pathogens like *Clostridioides difficile* notoriously difficult to treat. Researchers are exploring novel approaches, such as enzymes that degrade the wall’s peptidoglycan, to enhance drug efficacy. For DIY enthusiasts, this highlights the importance of thorough sterilization—boiling water alone may not suffice to kill spores; pressure cooking or chemical disinfectants are more reliable.
In conclusion, the thick cell wall of spores is a marvel of evolutionary engineering, balancing strength with adaptability. Its role in protection is not just passive resistance but an active defense against environmental threats. Whether you’re a scientist, farmer, or home canner, understanding this structure offers practical insights into combating or leveraging spore resilience. After all, nature’s designs often hold the keys to solving human challenges.
Can C. Diff Spores Spread Through Urine? Facts and Risks
You may want to see also

Dormancy Mechanism: Spores enter a dormant state, reducing metabolic activity to survive harsh conditions
Spores, the resilient survival units of various organisms, employ a remarkable strategy to endure environmental extremes: dormancy. This mechanism is not merely a passive state of inaction but a highly regulated process that ensures their longevity. When faced with adverse conditions such as extreme temperatures, desiccation, or nutrient scarcity, spores initiate a metabolic slowdown, reducing their energy consumption to a bare minimum. This strategic reduction in metabolic activity allows them to persist for extended periods, sometimes even centuries, until conditions become favorable again.
Consider the example of bacterial endospores, such as those formed by *Bacillus* species. These spores can withstand boiling temperatures, radiation, and harsh chemicals by entering a dormant state where their DNA is protected within a thick, multilayered coat. Metabolic activity drops to nearly undetectable levels, with some studies indicating a reduction of up to 99% compared to their active vegetative state. This near-complete shutdown of cellular processes is a testament to the efficiency of dormancy as a survival mechanism. For instance, endospores can survive in soil for decades, waiting for moisture and nutrients to return before reactivating.
The process of entering dormancy is not instantaneous but involves a series of biochemical changes. Spores accumulate protective molecules like dipicolinic acid, which stabilizes their DNA and proteins, and thicken their cell walls to resist physical and chemical stressors. This preparation phase is critical, as it determines the spore’s ability to withstand harsh conditions. For example, fungal spores, such as those of *Aspergillus*, produce melanin in their cell walls, which acts as a shield against UV radiation and oxidative stress. These adaptations highlight the proactive nature of dormancy, rather than a mere reaction to stress.
Practical applications of spore dormancy mechanisms are found in industries like food preservation and biotechnology. Understanding how spores survive desiccation has led to the development of freeze-drying techniques, which preserve vaccines and pharmaceuticals by mimicking the spore’s ability to withstand dryness. Similarly, studying spore dormancy has inspired methods to control foodborne pathogens, such as *Clostridium botulinum*, by targeting their ability to form dormant spores. For home preservation, knowing that spores can survive boiling water underscores the importance of using pressure canners, which reach temperatures above 100°C, to destroy them effectively.
In conclusion, the dormancy mechanism of spores is a masterclass in survival efficiency. By drastically reducing metabolic activity and fortifying their structure, spores create a protective cocoon that defies environmental challenges. This strategy not only ensures their persistence but also offers valuable insights for technological and scientific advancements. Whether in nature or industry, the dormant spore remains a symbol of resilience, reminding us of life’s ingenuity in the face of adversity.
Are Spores on Potatoes Safe to Eat? A Complete Guide
You may want to see also

Pigmentation: Dark pigments in spores protect against UV radiation, preventing DNA damage
Spores, the resilient survival structures of various organisms, employ a range of strategies to endure harsh environmental conditions. One such mechanism is the use of dark pigments, which act as a shield against the damaging effects of ultraviolet (UV) radiation. This natural defense system is particularly crucial for spores exposed to direct sunlight, where UV rays can wreak havoc on their genetic material.
The Science Behind Pigmentation
Melanin, a common dark pigment found in many spore-producing organisms, is a key player in this protective process. Its complex molecular structure enables it to absorb a broad spectrum of UV radiation, effectively converting it into harmless heat energy. This absorption capacity is not limited to a specific wavelength; melanin can protect against both UVA and UVB rays, which are known to cause DNA damage and mutations. For instance, studies have shown that spores of the fungus *Aspergillus nidulans* with higher melanin content exhibit significantly reduced DNA damage when exposed to UV radiation compared to their lighter counterparts.
A Natural Sunscreen
Imagine a natural sunscreen, but one that is inherently part of the spore's structure. This is precisely what dark pigmentation offers. The effectiveness of this protection is evident when comparing spores with varying pigment levels. In a controlled experiment, researchers exposed *Bacillus subtilis* spores with different melanin concentrations to UV radiation. The results were striking: spores with higher melanin content retained their viability, while those with less pigment suffered substantial DNA damage, leading to reduced germination rates. This demonstrates that pigmentation is not just a cosmetic feature but a critical survival adaptation.
Practical Implications and Applications
Understanding this protective mechanism has practical implications, especially in industries where spore survival is essential. For example, in agriculture, ensuring the viability of spore-based bio-pesticides or fertilizers is crucial for their effectiveness. By manipulating pigmentation levels, manufacturers can enhance the UV resistance of these products, improving their performance in outdoor conditions. Additionally, this knowledge can be applied in space exploration, where spores could be used as a model for understanding how life might adapt to the extreme UV radiation present on other planets.
A Comparative Perspective
The use of pigmentation for UV protection is not unique to spores; it is a strategy employed by various life forms. For instance, the dark plumage of some bird species and the skin pigmentation in humans serve similar purposes. However, the concentration and type of pigments in spores are often more specialized, reflecting their need to survive in diverse and extreme environments. This comparative analysis highlights the efficiency and specificity of spore pigmentation as an evolutionary adaptation.
In summary, dark pigments in spores act as a natural barrier against UV radiation, safeguarding their genetic integrity. This mechanism is a testament to the ingenuity of nature's designs, offering insights that can be applied across various scientific and industrial domains. By studying these protective strategies, we not only gain a deeper understanding of spore biology but also unlock potential innovations in fields ranging from agriculture to astrobiology.
Do Mold Spores Float in the Air? Unveiling the Truth
You may want to see also
Explore related products

Small Size: Compact size minimizes surface area, reducing exposure to harmful environmental factors
Spores, the resilient survival structures of various organisms, leverage their diminutive size as a primary defense mechanism against environmental threats. Measuring mere microns in diameter, spores present a minimal surface area to the external world. This compactness is not merely a coincidence but a strategic adaptation. By reducing their exposed surface, spores limit the entry points for harmful agents such as UV radiation, desiccating winds, and toxic chemicals. Imagine a fortress with fewer walls to breach—its defenses are inherently stronger. This principle applies to spores, where their small size acts as a natural barrier, minimizing vulnerability to environmental stressors.
Consider the practical implications of this design. For instance, fungal spores, often smaller than 10 micrometers, are less likely to be damaged by UV-C radiation, which is lethal to larger microorganisms. This size advantage allows them to persist in environments where larger organisms would perish. Similarly, bacterial endospores, with their compact, dehydrated cores, can withstand extreme conditions, including heat, radiation, and chemicals, due to their reduced surface area. This adaptability is not just theoretical; it’s a survival strategy honed over millennia, ensuring spores can endure until conditions improve.
To illustrate further, compare a spore to a large leaf exposed to the same environmental conditions. The leaf, with its expansive surface area, is susceptible to rapid water loss, temperature fluctuations, and physical damage. In contrast, a spore’s compact structure retains moisture more efficiently and dissipates heat quickly, maintaining internal stability. This efficiency is critical in harsh environments, such as deserts or polar regions, where survival hinges on minimizing exposure to adverse factors. For those studying or utilizing spores, understanding this size-based protection can inform strategies for preservation, dispersal, and even synthetic biology applications.
From a practical standpoint, leveraging the small size of spores can enhance their effectiveness in various applications. For example, in agriculture, smaller spores of beneficial fungi or bacteria can be more evenly distributed across crops, ensuring better coverage with less material. In biotechnology, designing spore-like structures with minimal surface area could improve the durability of bioengineered organisms in challenging environments. However, caution is necessary; while small size offers protection, it also limits nutrient absorption and metabolic activity. Balancing these trade-offs is key to optimizing spore-based solutions.
In conclusion, the small size of spores is a masterclass in biological efficiency, demonstrating how minimalism can maximize survival. By reducing surface area, spores create a protective shield against environmental hazards, ensuring their longevity in even the harshest conditions. This principle not only explains their resilience but also inspires innovative approaches in fields ranging from agriculture to biotechnology. Whether you’re a researcher, farmer, or enthusiast, appreciating this adaptation can unlock new possibilities for harnessing the power of spores.
Exploring Moss Reproduction: Do Mosses Produce Two Distinct Types of Spores?
You may want to see also

Resistant Coatings: Spores produce protective layers like exosporium to resist heat, chemicals, and desiccation
Spores, the resilient survival structures of certain bacteria, fungi, and plants, face extreme environmental challenges. To endure, they employ a sophisticated defense mechanism: resistant coatings. These layers, such as the exosporium in bacterial spores, act as a fortress against heat, chemicals, and desiccation. Imagine a microscopic suit of armor, meticulously designed to shield the spore’s genetic material until conditions are favorable for growth. This protective strategy is not just a passive barrier but a dynamic system that adapts to threats, ensuring survival in the harshest environments.
One of the most remarkable features of these coatings is their ability to resist heat. For instance, bacterial spores like *Bacillus anthracis* can withstand temperatures exceeding 100°C for extended periods. This heat resistance is attributed to the exosporium’s protein-rich composition, which forms a cross-linked network that stabilizes the spore’s internal structure. Similarly, fungal spores, such as those of *Aspergillus*, utilize melanin-rich coatings that dissipate heat and protect against UV radiation. These adaptations are critical for spores that inhabit environments prone to temperature fluctuations, such as soil or decaying organic matter.
Chemical resistance is another key function of spore coatings. The exosporium acts as a selective barrier, repelling toxic substances like heavy metals, antibiotics, and disinfectants. For example, spores of *Clostridium botulinum* can survive exposure to high concentrations of ethanol and hydrogen peroxide, thanks to their impermeable outer layers. This resistance is particularly advantageous in environments where chemical exposure is common, such as industrial settings or contaminated water sources. Practical applications of this trait include the need for specialized sterilization techniques, such as autoclaving at 121°C for 15–30 minutes, to effectively eliminate bacterial spores in laboratory or medical equipment.
Desiccation, or extreme dryness, poses a significant threat to cellular life, but spore coatings excel in countering this challenge. The exosporium in bacterial spores and the cell wall layers in fungal spores trap residual water molecules, maintaining internal hydration. Additionally, these coatings often contain trehalose, a sugar that stabilizes proteins and membranes during dehydration. This dual-layered approach allows spores to survive in arid conditions for years, even decades. For instance, *Bacillus subtilis* spores have been revived after being dormant in the desert for over 25 million years, a testament to the effectiveness of their protective coatings.
Understanding these resistant coatings has practical implications beyond biology. Engineers and material scientists are drawing inspiration from spore structures to develop advanced protective materials. For example, exosporium-inspired coatings could enhance the durability of electronics in extreme conditions or improve the shelf life of pharmaceuticals. By mimicking nature’s designs, we can create solutions that withstand heat, chemicals, and desiccation, much like spores do. This intersection of biology and technology highlights the untapped potential of studying spore survival mechanisms.
Can Vinegar Kill Tetanus Spores? Debunking Myths and Facts
You may want to see also
Frequently asked questions
Spores have a thick, resistant cell wall made of materials like sporopollenin, which acts as an insulator, protecting them from both high and low temperatures.
Spores enter a dormant state with minimal metabolic activity and reduced water content, allowing them to withstand desiccation and harsh, arid conditions.
Many spores contain pigments like melanin or carotenoids that absorb or block harmful UV radiation, shielding their genetic material from damage.
Spores have a robust outer layer that is impermeable to many chemicals, preventing toxins and other harmful substances from entering and damaging their internal structures.
Spores remain dormant until conditions improve, requiring minimal nutrients and energy to survive for extended periods in unfavorable environments.

























